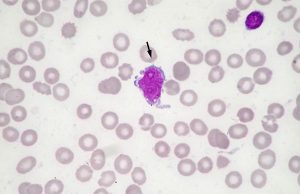

Etiket: kan kanseri
Astrazeneca Türkiye Çalışanlarından, Kan Kanserine Karşı “Birlikte Güçlüyüz” Mesajı
Astrazeneca Türkiye Çalışanlarından, Kan Kanserine Karşı “Birlikte Güçlüyüz” Mesajı
CAR-T Hücre Tedavileri, Daha Önce Tedavi Edilemeyen Kan Kanserlerinin Tedavisini Dönüştürüyor
lösemide CAR-T Hücre Tedavileri
Sessiz İlerleyen Kronik Lenfositik Lösemiye Dikkat!
Sessiz İlerleyen Kronik Lenfositik Lösemiye Dikkat!
Bana Bir Kanser Teşhisi Konulursa, Başka Bir Kansere Yakalanma Olasılığım Var...
Başka Bir Kansere Yakalanma Olasılığım
Türünün İlk Örneği Olan Terapi, Kök Hücre Nakli Sonrası Bağışıklık Saldırısını...
Bir klinik araştırmada, "türünün ilk örneği" bir tedavinin, kemik iliği naklinden kaynaklanan ciddi bağışıklık saldırılarını önleyebileceğini öne sürüyor.
“Erişkin Lösemi Hastaları Günü” Umut Dolu Hikayelerle Kutlandı
Dünyada her yıl yaklaşık 500.000 kişiyi etkileyen ve 300.000’de fazla insanın hayatını kaybetmesine neden olan Lösemi ile ilgili ülkemizde de farkındalık yaratılması amacıyla...